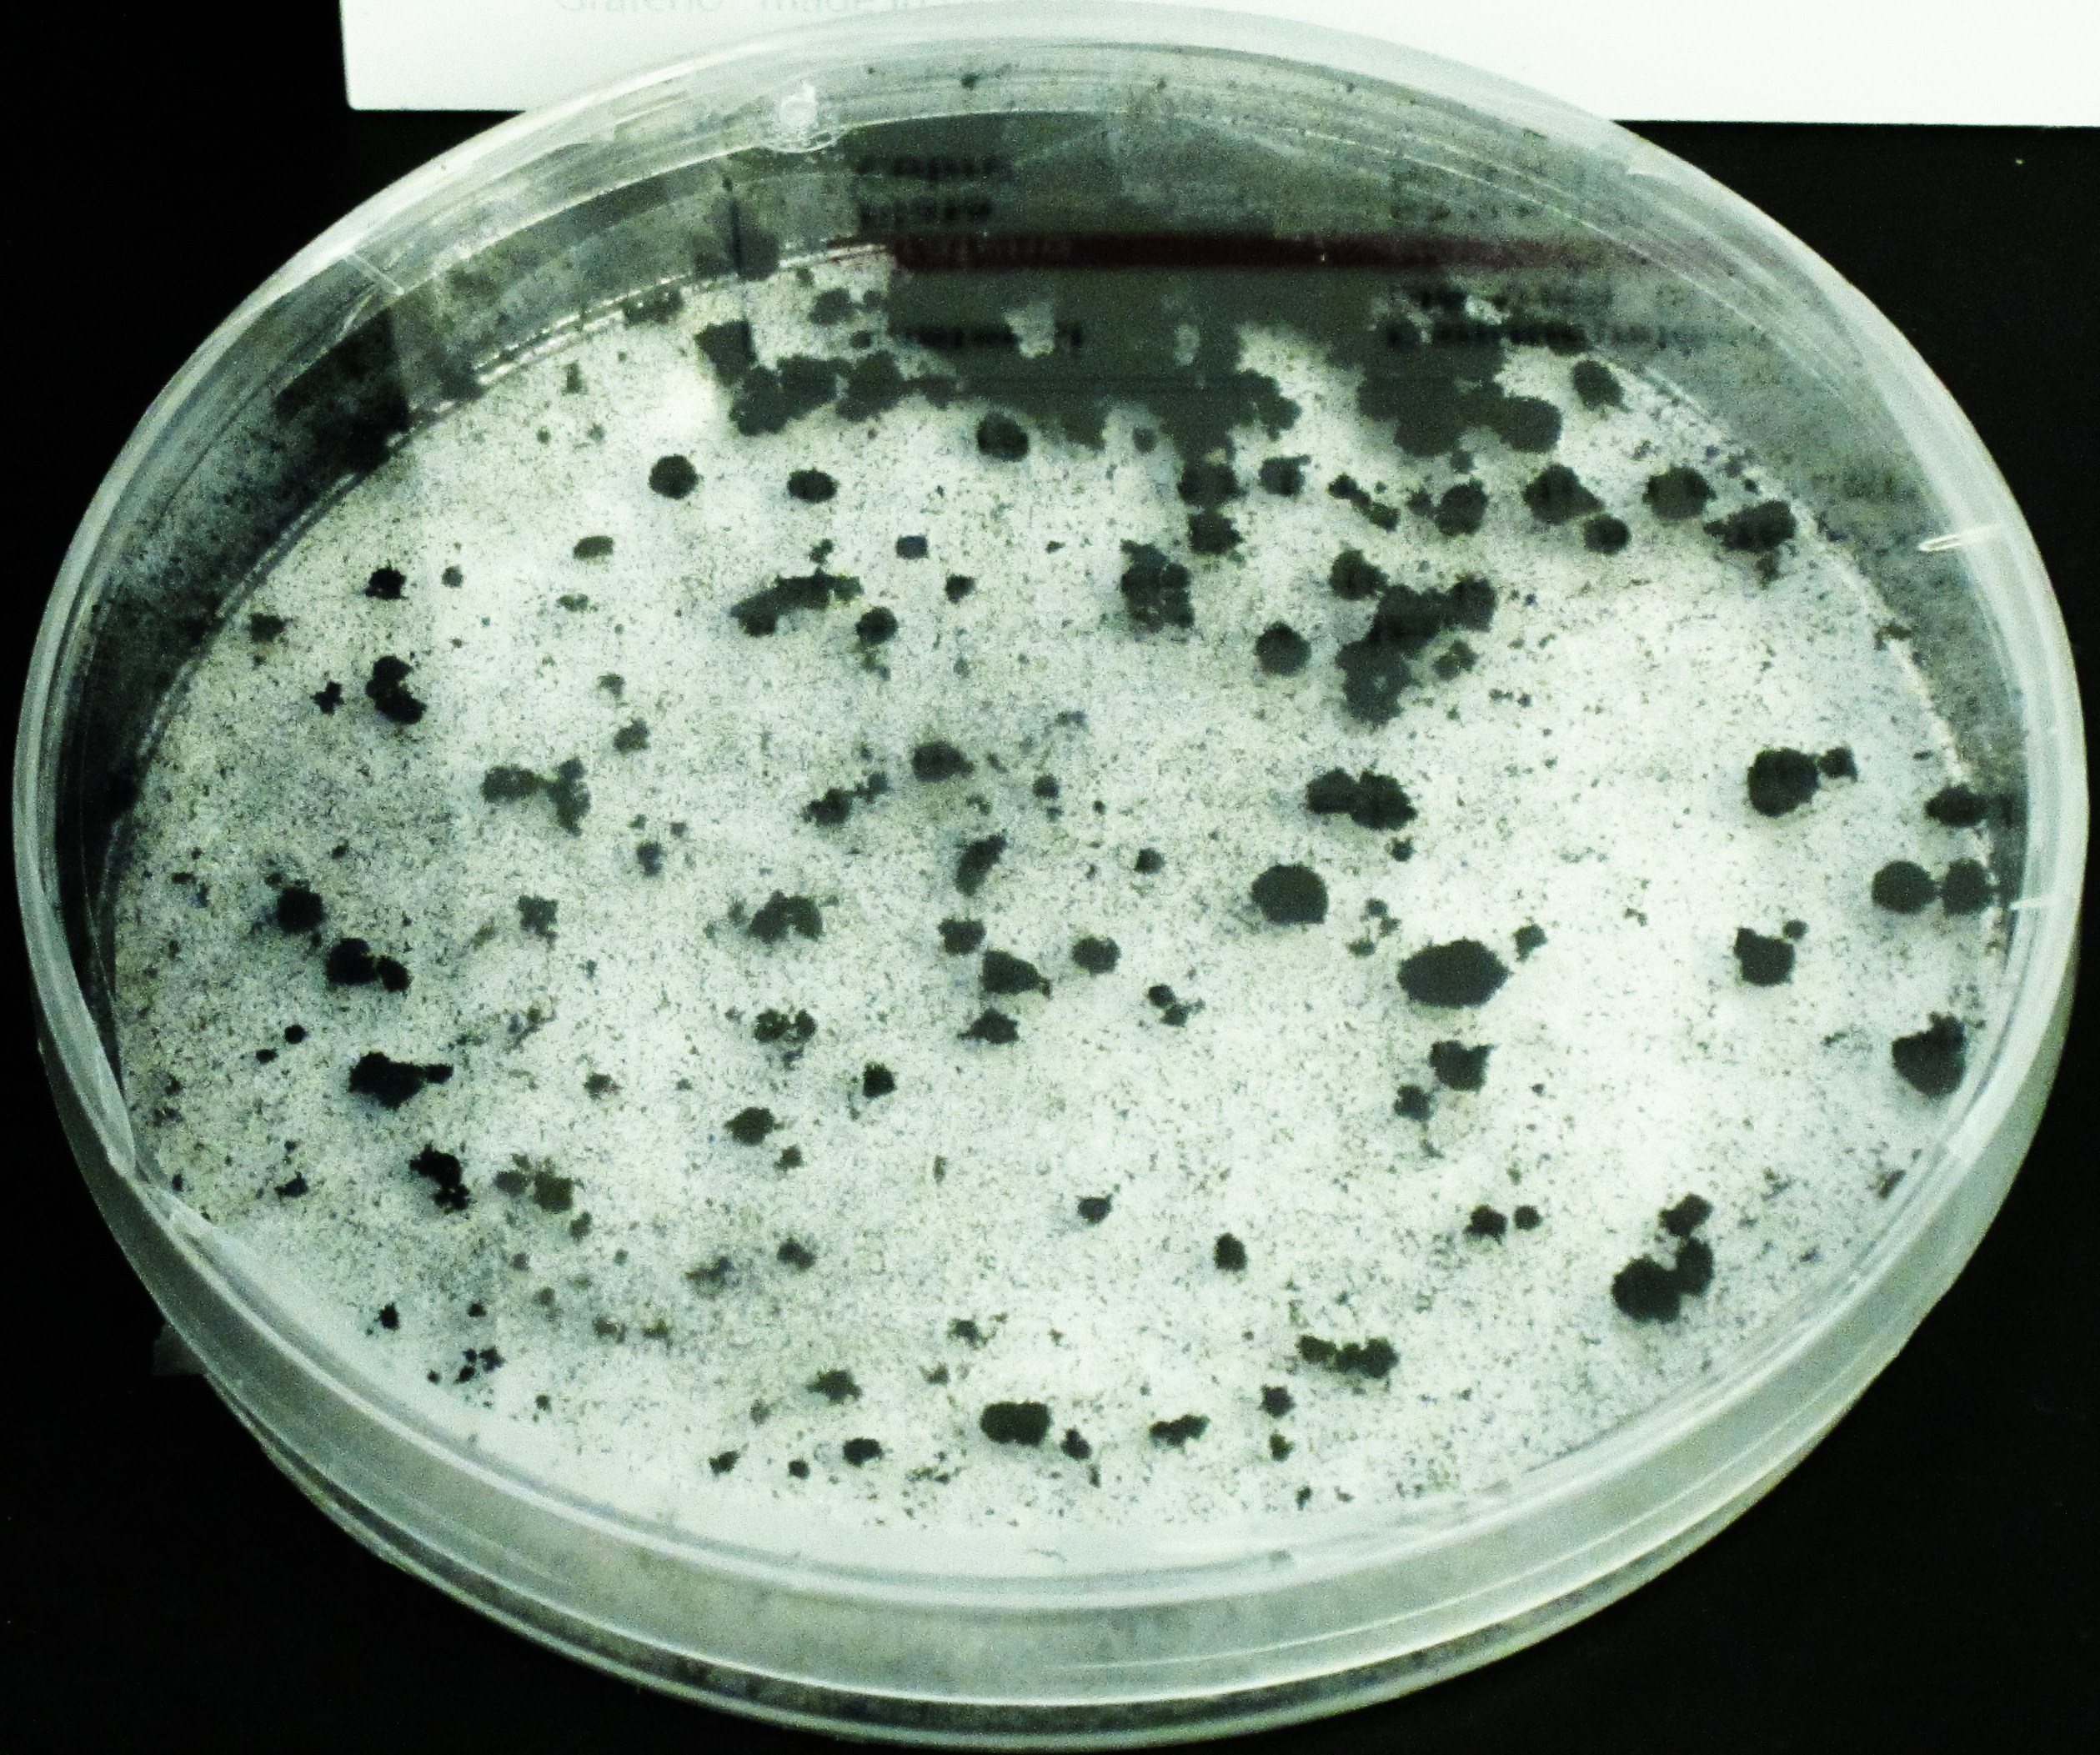
IMG_2094

Etiquetas
ADN, Alzheimer, Biología Molecular, CBM, Genética, Laura Gil Alberdi, terapia, UAM, UAX

Investigadora / Fuente: José Félix Rodríguez
“Mi mundo es la genética, es como que vibro con el ADN”
Laura Gil Alberdi es Bióloga Molecular por la UAM (Universidad Autónoma de Madrid) y profesora de Genética Humana en la Universidad Alfonso X El Sabio y está investigando sobre el tratamiento del Alzheimer.
La ciencia y el conocimiento forman parte de su vida y también le gusta la psicología, el arte, la filosofía y la sociología.
1. ¿Por qué estudió Biología Molecular?
Porque en los tiempos que me tocó estudiar, no existía la genética, que entonces era lo que me gustaba. Me incorporé en la Universidad Autónoma en el segundo ciclo, en cuarto y quinto, en la especialidad de “Biología Molecular” y era cuando se estaba creando el centro de Biología Molecular.
“La bacteria es, en sí misma y desde mi punto de vista, el prototipo biológico más “low cost” potencialmente que existe.»
2. ¿Qué recuerda con más interés de su paso por la Universidad Autónoma?
Siempre he guardado un gran recuerdo de esos dos años que pasé allí. Era una experiencia que se “sentía”, la “efervescencia de los profesores”, estar al lado del nobel Severo Ochoa, tener a Eladio Viñuela hablándonos de fisicoquímica, a García Bellido descubriéndonos el desarrollo de las moscas o a Fernando Valdivieso con todo el servicio de “metabólica”… fueron “momentos gloriosos”; Margarita Salas, el CBM…era algo impresionante.
“El envejecimiento actualmente no se puede parar, pero sí se puede ralentizar”
- En la historia de la ciencia, han supuesto grandes cambios tanto la aparición del método científico como el investigar en equipo, ¿hacia dónde vamos?
Sin lugar a duda el método científico fue la gran herramienta que considero que ha hecho que la ciencia dé un paso enorme. Hemos vivido una situación
histórica: “la pandemia”. La pandemia paralizó el mundo; la Tierra dejó de girar en cuanto a “civilización”.
Actualmente, la genómica permite tratar al paciente en el Hospital sabiendo exactamente cuáles son sus variantes alélicas que van a determinar un tipo de “ farmacogenética” y un tipo de pronóstico
“el hospital virtual es como una lección de un libro, pero en vivo”
- ¿Qué desafíos tiene la ciencia en los próximos años, en concreto la Medicina y la genómica? Ahora se oye mucho hablar de los algoritmos y la IA… ¿genética a la carta?
Mi mundo es la genética, vibro con el ADN. Se llama “medicina genómica” y los médicos la han transformado en la llamada “medicina de precisión”. Yo creo que éste es uno de los campos en los que la “Inteligencia Artificial IA» va a tener mayor eclosión, lo está teniendo ya. ¿Por qué? Porque la utilización del “ Big Data”, junto con la IA, e incluso los “ algoritmos inductivos”, van a traer a una transformación a todos los niveles del mundo de la salud: de la salud humana, de la salud de los animales, de la salud del Planeta.
A partir de ahora vamos a hablar de la “ genómica reproductiva” de la “ nutrigenómica”, de la “farmacogenómica”, que ya está aquí, “la genómica
metabólica” que hay que desarrollarla junto con la “nutrigenómica”, sin contar con la “genética comparativa”, ya englobando la gran “pirámide biológica” con la interrelación de todos los genomas.
“Las mujeres siempre hemos estado en la ciencia, solo que no nos han dejado ser muy visibles”
En la “pirámide biológica” y en “una pirámide genómica” de fenotipos hay una interrelación no solo horizontal por donde fluyen los genomas sino también vertical y entonces es el “proceso evolutivo” en sí mismo, como todo tiene su “cara B” o una parte de “cara B”.

Laboratorio de prácticas de Genética / Fuente: José Félix Rodríguez
La bacteria es en sí misma desde mi punto de vista el prototipo biológico “low cost” potencialmente que existe, pero no es solo eso, sino que nosotros no podemos vivir sin bacterias, porque nosotros en nuestro cuerpo biológico tenemos más procariotas; y somos ambas cosas, somos simbiosis. Eso lo contaba Teilhard de Chardin: él utilizaba una “noogenesis” englobando todos los seres vivos del Planeta Tierra.
Un gran campo de la Genética es l as enfermedades “raras”, constituyen “grandes retos”. Porque como yo digo a mis alumnos, las enfermedades que estudiamos en “genética médica”, no son las únicas, son las que logran ser “viables”; y desconocemos todas las que son “letales”. Eso evidentemente es un reto, y “eso son las enfermedades raras”: retos. Es un error considerar que son la excepción del “Big Data». Justamente esa es la fuente más creativa, porque es la pista que te va dando la naturaleza de que hay algo que ni las máquinas ni los algoritmos pueden hacer.
- El diagnóstico de la enfermedad de Alzheimer en las primeras etapas del proceso ayuda a preservar el funcionamiento del cerebro, ¿qué papel ocupa en la «medicina de precisión” la creación de medicamentos innovadores con nuevos biomarcadores?
Gran parte del mundo científico se centra en el diagnóstico pero lo importante no es el diagnóstico sino el tratamiento. Después de llevar doce
años inmersa en el estudio de esta patología, voy a salir de mi “zona de confort científica” y aportar algo más a la sociedad, hacer la ciencia que repercute más directamente, creando una “Startup” focalizada en el tratamiento del Alzheimer.
Hilando con lo que me has preguntado antes sobre mi investigación: “los biomarcadores”. Todos los tratamientos han ido encaminados a los “biomarcadores” de esa patología “citoesquelética” directamente relacionada con fenotipos clínicos muy críticos, con realmente estadios muy avanzados de la “demencia senil” y de falta de memoria: “un deterioro cognitivo grave.
Nuestra investigación ha puesto algunos de esos marcadores y otros nuevos en la patología nuclear de las neuronas tanto en el inicio y como en el pre-inicio de la enfermedad de Alzheimer (Alzheimer esporádico, que está directamente asociado con la edad), Es decir, en un cerebro “senil”, que es la condición en los esporádicos para que pueda desarrollarse la patología Alzheimer.

Neuronas con biomarcadores de sus investigaciones. Universidad de Catania./ Fuente: José Félix Rodríguez
Hemos encontrado que dos biomarcadores tempranos de la patología nuclear de neuronas con fenotipo Alzheimer son la expresión anómala de
proteína lamin A y la salida del núcleo de Fosfo-Tau. La ausencia de Lamin A en el núcleo de las neuronas es determinante para la plasticidad del núcleo-citoesqueleto y su funcionalidad sináptica. De hecho en los niños con progeria de Hutchinson-Gilford que tienen mutado el gen de lamin A no hay afectación cognitiva. La presencia de Fosfo-Tau en el citoplasma genera la aparición de los ovillos fibrilares tóxicos desarrollándose progresivamente la patología citoesquelética característica de los estadios intermedios y tardíos de Alzheimer.
Todos estos biomarcadores están publicados, lo que constituye nuestra hipótesis: “que la enfermedad de Alzheimer se inicia 8 o 10 años antes en lo que se
denomina según los estadios de “Braak and Braak”, estadios tempranos que son colindantes con “el estadio senil”, el cerebro senil.
“estoy saliendo de mi zona de confort para crear una “Startup” focalizada en el tratamiento del Alzheimer”
Es muy interesante porque, hasta el momento, lo que hemos encontrado al analizar diferentes zonas, diferentes áreas del hipocampo y áreas
anexas directamente relacionadas con el desarrollo de la enfermedad de Alzheimer es que la patología nuclear se manifiesta sincrónicamente en todas las áreas que hemos estudiado, mientras que los clásicos estudios de patología de patología citoesquelética la aparición de los “tangles”, no lo son. Me estoy refiriendo en este caso continuamente a “la patología de TAU”, no estoy hablando de la patología B-amiloide de placas, la patologíacitoesquelética de TAU está descrita que va progresando, bueno curiosamente nosotros hemos encontrado que la patología nuclear es “sincrónica”.
Hay que ver por qué, qué hace que se transforme. En las dianas que tenemos que ver cómo podemos ralentizarlas. Pararlo no lo sé, es algo en
el envejecimiento actualmente no se puede parar, pero si se puede ralentizar.
6.En la Universidad Alfonso X el Sabio han creado un Hospital Virtual de Simulación, dotado de las últimas tecnologías, ¿cree que el universitario formado en biotecnología tiene que anticipar las soluciones para prevenir la enfermedad?
He visto como han desarrollado el hospital y, lo han implantado, y creo que la Universidad Alfonso X el Sabio, ha proporcionado una gran herramienta al grado de medicina con este “hospital virtual”, entrando en la “programación” desde muy temprano en el conocimiento y la práctica de situaciones de patologías agudas, críticas en lo que es el ambiente de la UCI, de un quirófano en donde se va a hacer una intervención rápida y extrema, o una sala de partos, etc.…
El hospital virtual es como una lección de un libro, pero en vivo.
7. ¿Cómo ve la posición de «la científica» en la sociedad actual cree que tiene más dificultades por ser mujer para investigar en España?
Estoy muy contenta porque mis grados de medicina y biomedicina están llenos de mujeres. Curiosamente quizá esa tarea ancestral de educadoras, esa “impronta” va acompañada del conocimiento, del querer conocer. Otra cosa es cuando luego se desarrollan las carreras, cuántas de ellas, cuántas de nosotras, van a llegar a ocupar puestos organizativos.
En mi vida personal cuando había terminado mi tesis doctoral opté voluntariamente por otras experiencias: me fui a crear una familia y fue temporal, todo es temporal- La ciencia la retomé cuando me convertí en una “científica independiente».
Las mujeres que estamos ya en la ciencia sin lugar a duda, siempre hemos estado, solo que tampoco nos han dejado ser muy visibles. O sea, el señor Einstein tenía una esposa que era científica, el señor Lavoisier tenía una esposa que era científica, la señora Hedy Lamarr aparte de ser bellísima y una gran estrella de Hollywood ayudó a los americanos en la Segunda Guerra Mundial y fue la precursora del Wifi. En la medida en que los hombres asuman crear una familia igual que lo hace una mujer; se rompan los roles; y solo existan voluntades de crecer algo; eso va a permitir que las mujeres puedan acceder mucho más fácilmente a los puestos de dirección.
La investigadora agradece la colaboración del “Banco de Cerebros del Hospital Universitario Fundación Alcorcón” (HUFA) en sus investigaciones.
Biobanco | Hospital Universitario Fundación Alcorcón (comunidad.madrid).